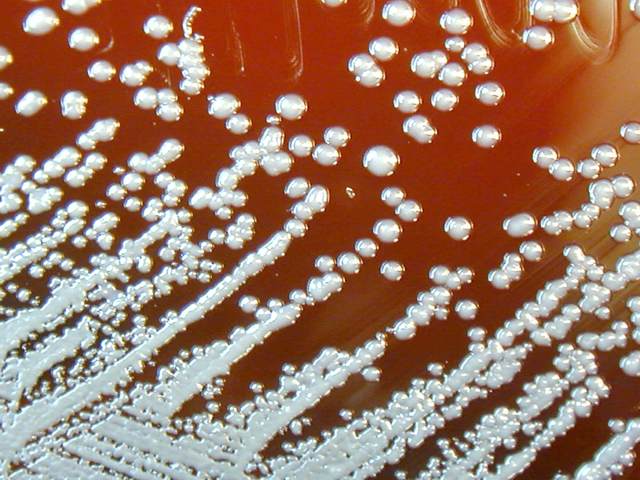
Burkholderia mallei in culture

Main menu
Common skin conditions
NEWS
Join DermNet PRO
Read more
Quick links
Author: Dr Catriona Wootton, Consultant Dermatologist, UK. DermNet Editor in Chief: Adjunct A/Prof Amanda Oakley, Hamilton, New Zealand. April 2019.
Introduction
Introduction
Demographics
Causes
Clinical features
Complications
Diagnosis
Differential diagnoses
Treatment
Prevention
Outcome
Melioidosis and glanders are infectious diseases caused by species of the bacterial genus Burkholderia. These infectious diseases differ in geographical range and ecology.
Glanders is a rare, sporadic disease caused by the bacterium Burkholderia mallei (this bacterium has been known by a variety of other names, such as Pseudomonas mallei, Actinobacillus mallei, Pfeifferella mallei, Malleomyces mallei, Corynebacterium mallei, Mycobacterium mallei, and Bacillus mallei).
Glanders is primarily a disease of horses, although it may occur in other animals. It is uncommon now that horses are used less frequently for transport, but it is sometimes seen in parts of Africa, Asia, the Middle East, and Central and South America. Infection with B. mallei may occur in people in direct contact with infected animals. The bacteria enter the body through an abrasion on the skin or via the mucosal surfaces of the eyes, nose, and respiratory tract. Cases of person-to-person transmission have rarely been reported. Glanders can prove fatal, and it is considered to be a potential biological warfare agent because it is highly infectious by inhalation.
Glanders is also known as farcy and malleus.
Anyone working closely with infected animals (mostly horses) or tissue from them, especially horses, is at risk of glanders: veterinarians, stable hands, laboratory workers, butchers, and abattoir workers.
B. mallei is a host-adapted derivative of B. pseudomallei, the cause of melioidosis. B. mallei bacteria are spread to humans and animals via contact with infected horses and other animals through skin abrasions, mucous membranes, or the inhalation of contaminated dust. Person-to-person transmission is rare.
The incubation period for glanders is around 1–14 days after infection. The clinical presentation will depend upon the mode of entry and it is similar to that of melioidosis. Symptoms common to all forms include fever, sweating, muscle ache, chest pain, and headache.
Localised infection is characterised by cutaneous inflammation with ulceration at the site of entry (a cut or scratch on the skin).
Glanders can result in pneumonia, lung abscesses, and pleural effusion due to direct inhalation or bloodborne spread.
In septicaemia due to glanders:
Multiple abscesses due to glanders may develop in the liver, spleen, lung, skin, or muscles.
Systemic infection may lead to multiple organ failure and death.
The diagnosis of glanders is confirmed by culture from blood, sputum, or other infected sites.
Be sure to inform the laboratory of the suspected or confirmed diagnosis.
Burkholderia mallei in culture
Credit: PIXNIO.
The differential diagnoses for glanders includes any infectious disease causing fever, headache, muscle pain with pneumonia, abscesses, or skin involvement. These diseases include:
As it is a bacterial infection, antibiotics are the mainstay of treatment for glanders. As the infection is rare in humans, there are currently no evidence-based treatment guidelines, but a similar treatment approach to that recommended for melioidosis should be adopted.
No vaccine is currently available for glanders. Prevention involves identifying and eradicating infecting animals in endemic areas and appropriate use of personal protective equipment in the healthcare setting and those dealing with potentially infected animals.
Glanders carried a high fatality rate in the pre-antibiotic era, but there have been few human cases since the introduction of antibiotics. It is expected that the outcomes for glanders would be similar to those seen in melioidosis.
Spickler, Anna Rovid. Glanders. At http://www.cfsph.iastate.edu/DiseaseInfo/disease.php?name=glanders&lang=en. Accessed April 16, 2019.